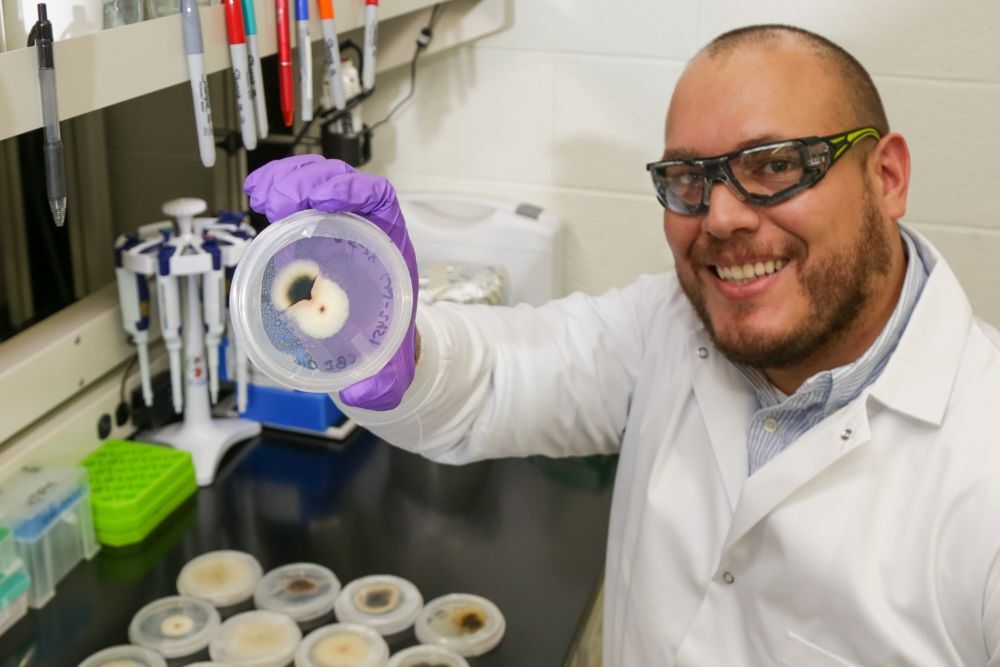

News from October 2022
By Press release submission | Oct 19, 2022
Yesterday, U.S. Senator Joe Manchin (D-WV), Chairman of the Senate Energy and Natural Resources Committee, called on President Biden to take all immediate actions within his authority to increase domestic energy production following an agreement from the Organization of Petroleum Exporting Countries+ (OPEC+) to cut oil production by 2 million barrels per day.
By Press release submission | Oct 19, 2022
Today, Rep. Gerry Connolly, Chairman of the Subcommittee on Government Operations, sent a letter to Postmaster General Louis DeJoy seeking information on the poor delivery service in North Carolina’s Research Triangle Park (RTP).
By Press release submission | Oct 19, 2022
Today, Rep. Carolyn B. Maloney, Chairwoman of the Committee on Oversight and Reform, sent a letter to Kimberly Cheatle, Director of the United States Secret Service, requesting compliance with the Committee’s request for a full accounting of the Secret Service’s spending at Trump-owned properties during former President Trump’s presidency.
By Press release submission | Oct 19, 2022
Today, Rep. Carolyn B. Maloney, Chairwoman of the Committee on Oversight and Reform, sent a letter to Postmaster General Louis DeJoy requesting information on the Postal Service’s plans to use funding made available by the Inflation Reduction Act and the Bipartisan Infrastructure Law to expand its fleet of electric vehicles (EV) and work with federal and state partners to help create a nationwide public EV charging network.
By Press release submission | Oct 19, 2022
Today, Rep. Ro Khanna, Chairman of the Subcommittee on Environment, and Rep. Zoe Lofgren issued the following statements after the Environmental Protection Agency (EPA) announced a proposed endangerment finding that lead emissions from aircraft that operate on leaded fuel cause or contribute to air pollution that may endanger public health
By Press release submission | Oct 19, 2022
House Committee on Oversight and Reform Ranking Member James Comer (R-Ky.) and House Committee on the Judiciary Ranking Member Jim Jordan (R-Ohio) today are pressing Acting Archivist of the United States Debra Steidel Wall about the possibility of the National Archives and Records Administration (NARA) being pressured by Oversight Committee Democrats to pursue former President Trump.
By Press release submission | Oct 19, 2022
Today, House Republican Whip and Select Subcommittee on the Coronavirus Crisis Ranking Member Steve Scalise (R-La.), House Committee on Oversight and Reform Ranking Member James Comer (R-Ky.), and House Committee on the Judiciary Ranking Member Jim Jordan (R-Ohio) are pressing Dr. Anthony Fauci about the National Institute for Allergy and Infectious Diseases (NIAID) awarding EcoHealth Alliance a new grant to study bat coronaviruses in Asia
By Press release submission | Oct 19, 2022
Today, House Committee on Oversight and Reform Ranking Member James Comer (R-Ky.) and several Oversight Committee Republicans are pressing U.S. Attorney General Merrick Garland about the collective failures by the U.S. Department of Justice (DOJ) and U.S.
By Press release submission | Oct 19, 2022
Tomás Rush: Decoding the secret language of plants and fungi

By Press release submission | Oct 19, 2022
DOE Funds Pilot Study Focused on Biosecurity for Bioenergy Crops

By Press release submission | Oct 19, 2022
Berkeley Lab Beginnings: Dr. Michelle Kuchera
By Press release submission | Oct 19, 2022
A Trial Run For Smart Streaming Readouts
By Press release submission | Oct 19, 2022
NERSC Summer Student Enhances Genomic Sequencing Alignment on GPU Architectures
By Press release submission | Oct 19, 2022
Envisioning the Battery Data Genome, a central data hub for battery innovation
By Press release submission | Oct 19, 2022
Earth System Grid Federation launches effort to upgrade climate projection data system
By Press release submission | Oct 19, 2022
New research center raises bar in Fermilab’s mission to go green
By Press release submission | Oct 19, 2022
Getting to Know LPO: How Investors Can Invest in LPO Projects
By Press release submission | Oct 19, 2022
Medium- and Heavy-Duty Vehicles Eligible for Advanced Technology Vehicles Manufacturing Loan Program




